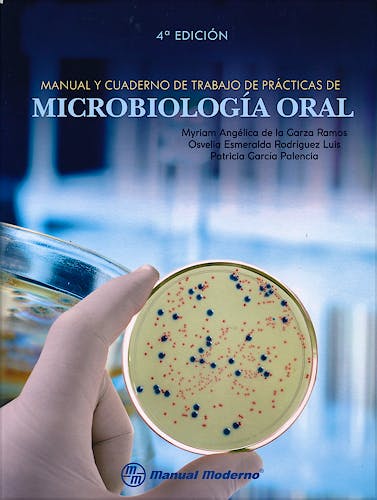

No hay productos en el carrito

Manual y Cuaderno de Trabajo de Prácticas de Microbiología Oral
de la Garza, M.A. — Rodríguez, O. — García, P.
4ª Edición Octubre 2017
Español
Tapa blanda
187 pags
555 gr
21 x 28 x 1 cm
ISBN 9786074486339
Editorial MANUAL MODERNO
LIBRO IMPRESO
-5%
38,30 €36,39 €IVA incluido
36,83 €34,99 €IVA no incluido
Recíbelo en un plazo de
3 - 4 días
Colaboradores
Agradecimientos
Manual
Práctica 1. Normas de trabajo en el laboratorio de microbiología, instrumental básico, manejo del asa bacteriológica
Práctica 2. Transferencia de bacterias de tubo a tubo
Práctica 3. Coloración simple. Preparación de una extensión en el portaobjetos
Práctica 4. Demostración de la presencia de microorganismos en la naturaleza
Práctica 5. Movilidad bacteriana
Práctica 6. Técnica de coloración diferencial. Tinción de Gram
Práctica 7. Coloración de esporas y cápsula bacteriana
Práctica 8. Cápsula bacteriana
Práctica 9. Separación de dos especies bacterianas de un cultivo mixto
Práctica 10. Efecto de los antibióticos en la proliferación bacteriana
Práctica 11. Cultivo de bacterias de caries dental
Práctica 12. Aislamiento de biota subgingival (microflora) subgingival
Práctica 13. Reacción en cadena de la polimerasa (PCR)
Práctica 14. Identificación de anticuerpos en sangre. Proteína C reactiva (CRP)
Práctica 15. Prueba para la determinación del riesgo de caries
Práctica 16. Extractos de plantas con efectos antimicrobianos aplicados a bacterias orales
Cuaderno de trabajo
Introducción
Fase I. Microbiologia básica e inmunología
Fase II. Ecología oral y caries dental
Fase III. Enfermedad periodontal, virología y micología
Índice
El Manual y cuaderno de trabajo de prácticas de microbiología oral, 4ª edición, tiene como objetivo el que los estudiantes de odontología y de otras ciencias de la salud conozcan las generalidades micro y macroscópicas de los principales microorganismos relacionados con la práctica clínica, y cuya intención es mejorar en la práctica clínica.
Esta obra se compone de numerosas imágenes que describen los principales materiales y procedimientos que forman parte de la práctica cotidiana en el laboratorio de microbiología. Asimismo, hay una serie de prácticas y ejercicios para trabajar de manera didáctica el contenido del libro.
El Manual y cuaderno de trabajo de prácticas de microbiología oral, 4ª edición, es un libro que retoma los fundamentos, estrategias y recomendaciones para cualquier interesado en el área de ciencias de la salud.
© 2025 Axón Librería S.L.
2.149.0